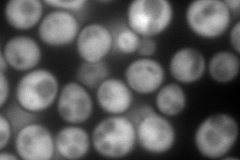
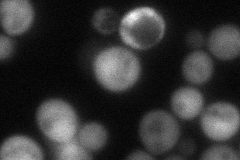

View description
Member of the p14.5 protein family with similarity to Mmf1p, functionally complements Mmf1p function when targeted to mitochondria; heat shock inducible; high-dosage growth inhibitor; forms a homotrimer in vitro
Localization:
Intensity:
Fold change:
Significance:
-
C’ GFP library in SD

cytosol19.79 -
N' NOP1pr-GFP in SD
cytosol406.74 -
N' TEF2pr-mCherry in SD

cytosol726.181 -
N' NATIVEpr-GFP in SD
cytosol70.2333 -
N' TEF2pr-VC and Cyto-VN in SD

#N/A0 -
C’ GFP library in SD+DTT

cytosol21.161.06No -
C’ GFP library in SD+H2O2

cytosol15.820.79No -
C’ GFP library in Starvation Media

cytosol56.932.87No -
C’ GFP library on the background of Pup2-DaMP

cytosol -
C’ GFP library on the background of CCT mutant

cytosol15.5970.787758No
